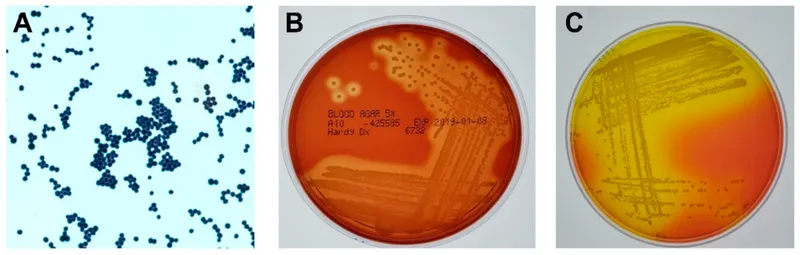
Bacterial culture showing Staphylococcus aureus colonies from orbital abscess specimen

Enter your email to get your 85% OFF code and unlock the full NEET PG question bank on the app.
The orbit is more than a bony socket-it's a complex fortress housing the eye, muscles, nerves, vessels, and fat, each vulnerable to infection, inflammation, tumors, and trauma. You'll learn to distinguish preseptal from orbital cellulitis, recognize thyroid eye disease's inflammatory cascade, identify space-occupying lesions from benign dermoids to malignant lymphomas, and understand how vascular anomalies and traumatic injuries threaten vision. Mastering orbital diseases means protecting sight by recognizing when inflammation becomes emergency, when a mass demands biopsy, and when surgical intervention saves the eye.
A neurosurgeon navigates 47 distinct anatomical structures within a 50ml orbital space, requiring sub-millimeter precision to avoid catastrophic complications. This extraordinary spatial complexity defines the orbital cavity as medicine's most densely packed anatomical region, where every cubic millimeter contains critical neurovascular structures that determine vision, eye movement, and facial sensation.
The orbital cavity functions as a sophisticated 7-walled bony fortress protecting the globe while accommodating 6 extraocular muscles, 3 major nerve pathways, and 12+ vascular channels. Understanding this architectural masterpiece unlocks the logic behind every orbital disease pattern, from infectious spread to tumor growth trajectories.
📌 Remember: SOILED - Sphenoid (greater wing), Orbital plate of frontal, Inferior orbital fissure, Lacrimal, Ethmoid, Down (maxilla + palatine). These 7 bones create the orbital walls, with the medial wall thinnest at 0.5mm (lamina papyracea) explaining why ethmoidal infections easily penetrate into orbit.
The orbital volume measures 30ml in adults, with the globe occupying 7ml (23%), leaving 23ml for extraocular muscles, fat, vessels, and nerves. This tight packing explains why any space-occupying lesion >2ml produces clinically evident proptosis or diplopia.
| Orbital Opening | Size (mm) | Key Structures | Clinical Significance | Pathology Risk |
|---|---|---|---|---|
| Optic Canal | 6 x 10 | Optic nerve, ophthalmic artery | 25% of orbital apex syndrome | Compressive optic neuropathy |
| Superior Orbital Fissure | 22 x 4 | CN III, IV, VI, V1, sympathetics | 60% of cavernous sinus syndrome | Diplopia, ptosis patterns |
| Inferior Orbital Fissure | 20 x 2 | Maxillary nerve, infraorbital vessels | 15% of floor fracture complications | Infraorbital numbness |
| Nasolacrimal Canal | 12 x 4 | Nasolacrimal duct | 80% of dacryocystitis cases | Epiphora, infection spread |
| Anterior Ethmoidal Foramen | 2 x 2 | Anterior ethmoidal vessels/nerve | 35% of medial wall fractures | CSF leak risk |
⭐ Clinical Pearl: The orbital apex syndrome presents with complete ophthalmoplegia + vision loss + V1 numbness, occurring in 8% of orbital tumors and 15% of invasive fungal sinusitis cases. The 5mm orbital apex concentrates all major neurovascular structures, making it the most dangerous orbital region.
💡 Master This: The muscle cone concept divides orbital space into intraconal (within rectus muscles) and extraconal (outside muscle cone) compartments. 75% of orbital tumors are intraconal, while 85% of orbital infections are extraconal. This anatomical distinction predicts clinical presentation patterns and surgical approaches.
The orbital septum serves as the critical barrier separating preseptal from orbital tissues. This 0.5mm thick fibrous membrane extends from the orbital rim to the tarsal plates, explaining why preseptal cellulitis (90% of pediatric orbital infections) rarely progresses to true orbital cellulitis when the septum remains intact.
📌 Remember: SCAN for orbital compartments - Septum (preseptal barrier), Cone (muscle cone), Apex (neurovascular convergence), Nasal (medial wall weakness). Understanding these anatomical boundaries predicts infection spread patterns and tumor growth trajectories.
Connect this anatomical foundation through vascular territories to understand how orbital diseases manifest with specific clinical patterns.
A cardiac surgeon monitors 300+ hemodynamic parameters during complex procedures, maintaining perfusion pressures within 5mmHg of target values. Similarly, the orbital circulation operates as a high-precision network where arterial inflow and venous drainage patterns determine disease manifestations, from thyroid orbitopathy congestion to arteriovenous malformation symptoms.
The ophthalmic artery provides 85% of orbital blood supply, branching into 10 major vessels within the 30ml orbital space. This dense vascular network creates unique hemodynamic relationships where venous congestion produces immediate clinical signs due to the orbit's rigid bony boundaries.
📌 Remember: LAMP POST for ophthalmic artery branches - Lacrimal, Anterior ethmoidal, Muscular, Posterior ethmoidal, Posterior ciliary, Optic nerve, Supraorbital, Terminal (dorsal nasal + supratrochlear). These branches supply 95% of orbital structures, with collateral circulation providing <5% backup flow.

The superior ophthalmic vein drains 70% of orbital venous blood, flowing posteriorly to the cavernous sinus without valves. This valveless system allows bidirectional flow, explaining how facial infections can spread retrograde into the orbit and cavernous sinus, causing cavernous sinus thrombosis in 2-5% of severe orbital cellulitis cases.

| Vascular Structure | Normal Flow (ml/min) | Pressure (mmHg) | Disease Changes | Clinical Threshold |
|---|---|---|---|---|
| Ophthalmic Artery | 50-80 | 80-120 systolic | ↓50% in giant cell arteritis | <25 ml/min = vision loss |
| Central Retinal Artery | 8-12 | 60-80 | ↓70% in CRAO | <3 ml/min = irreversible |
| Superior Ophthalmic Vein | 15-25 | 8-15 | ↑200% in AVM | >30 mmHg = proptosis |
| Posterior Ciliary | 20-35 | 70-90 | ↓40% in AION | <15 ml/min = optic ischemia |
| Lacrimal Artery | 5-8 | 75-95 | ↑300% in hemangioma | >25 ml/min = pulsatile mass |
⭐ Clinical Pearl: Orbital compartment syndrome occurs when intraorbital pressure exceeds 30mmHg, compromising optic nerve perfusion. This develops in 12% of orbital hemorrhages and 8% of severe thyroid orbitopathy cases, requiring emergency lateral canthotomy when vision deteriorates.
The arterial circle of Zinn-Haller surrounds the optic nerve head, formed by short posterior ciliary arteries. This 2mm diameter vascular ring provides 60% of optic disc blood supply, with watershed zones predisposing to anterior ischemic optic neuropathy when perfusion pressure drops below 40mmHg.
💡 Master This: The orbital steal phenomenon occurs in high-flow vascular lesions where >150ml/min arterial flow diverts blood from normal orbital structures. This creates relative ischemia of extraocular muscles and optic nerve, explaining diplopia and vision loss in 35% of arteriovenous malformations despite normal appearing tissues.
📌 Remember: VENOUS drainage complications - Valveless (bidirectional flow), Engorgement (thyroid disease), No collaterals (limited backup), Outflow (cavernous sinus), Under pressure (compartment syndrome), Spread (infection pathway). Understanding venous anatomy predicts 80% of orbital disease complications.
Connect these vascular patterns through inflammatory responses to understand how orbital diseases progress from localized to systemic manifestations.
An immunologist tracks 500+ inflammatory mediators during sepsis, monitoring cytokine levels every 30 minutes to predict organ failure cascades. The orbital inflammatory response follows similarly predictable patterns where initial triggers activate specific pathways leading to characteristic clinical presentations that enable rapid diagnosis and targeted treatment.
Orbital inflammation manifests through 4 distinct pathways: infectious, autoimmune, granulomatous, and neoplastic. Each pathway produces signature inflammatory markers and specific tissue changes that create recognizable clinical patterns, allowing "see X, think Y" diagnostic frameworks.

📌 Remember: SIGHT for inflammatory patterns - Septal involvement (preseptal vs orbital), Infiltrate type (neutrophils vs lymphocytes), Granulomas (sarcoid vs Wegener's), Hemorrhage (vasculitis), Tissue destruction (necrotizing vs non-necrotizing). These histologic patterns predict 85% of inflammatory orbital diseases.

⭐ Clinical Pearl: The orbital apex syndrome from sphenoid sinusitis presents with complete ophthalmoplegia + vision loss + V1 numbness in 8% of invasive fungal infections. Mucormycosis shows black eschar in 60% of cases and requires immediate surgical debridement plus amphotericin B to prevent 25% mortality rate.

| Inflammatory Type | Onset | Age Group | Key Features | Treatment Response |
|---|---|---|---|---|
| Preseptal Cellulitis | 24-48 hrs | Pediatric (70%) | Lid swelling, normal vision | Oral antibiotics 85% |
| Orbital Cellulitis | 48-72 hrs | All ages | Proptosis, diplopia, pain | IV antibiotics 75% |
| Orbital Abscess | 72-96 hrs | Adult (60%) | Fixed globe, vision loss | Surgery required 90% |
| Cavernous Sinus Thrombosis | 96+ hrs | Adult (80%) | Bilateral, cranial nerves | ICU management 100% |
| Necrotizing Fasciitis | 12-24 hrs | Immunocompromised | Rapid progression, systemic | Emergency surgery 100% |
💡 Master This: Steroid responsiveness differentiates inflammatory from neoplastic orbital disease in 90% of cases. Dramatic improvement within 48-72 hours of prednisolone 1mg/kg/day suggests inflammatory etiology, while <25% improvement indicates malignancy requiring tissue diagnosis.
The inflammatory cascade timeline follows predictable patterns: vasodilation (0-6 hours), cellular infiltration (6-24 hours), tissue edema (24-48 hours), and fibrosis (>72 hours). Understanding this progression enables targeted intervention at optimal therapeutic windows.
📌 Remember: FLAMES for orbital inflammation severity - Fever (systemic involvement), Leukocytosis (>15,000), Afferent pupil defect (optic nerve), Motility restriction (muscle involvement), Exposure keratopathy (lid dysfunction), Sinus involvement (source). ≥3 criteria indicate severe disease requiring aggressive treatment.
Connect these inflammatory patterns through infectious pathways to understand how orbital diseases spread and require specific antimicrobial strategies.
A microbiologist processes 200+ culture specimens daily, identifying pathogen resistance patterns within 6 hours using molecular diagnostics to guide targeted therapy. Orbital infections follow similar systematic patterns where organism type, anatomical location, and host factors create predictable clinical syndromes requiring specific diagnostic and therapeutic approaches.
Orbital infections demonstrate anatomical progression patterns from superficial to deep structures, with bacterial species varying by age group, anatomical site, and predisposing conditions. This systematic approach enables rapid pathogen prediction and empirical treatment selection.
📌 Remember: BUGS by location - Before septum (Staph/Strep), Under periosteum (anaerobes), Going deep (gram negatives), Sinus source (polymicrobial). Age <5 years: H. influenzae risk. Age >50 years: Mucormycosis in diabetics, Aspergillus in immunocompromised.

| Infection Type | Common Organisms | Antibiotic Choice | Duration | Success Rate |
|---|---|---|---|---|
| Preseptal Cellulitis | S. aureus (40%), Streptococcus (35%) | Clindamycin 300mg q8h | 7-10 days | 95% oral therapy |
| Orbital Cellulitis | S. aureus (35%), S. pneumoniae (25%) | Vancomycin + Ceftriaxone | 10-14 days | 85% IV therapy |
| Subperiosteal Abscess | Anaerobes (40%), S. aureus (30%) | Ampicillin-Sulbactam | 14-21 days | 75% medical, 90% surgical |
| Orbital Abscess | Polymicrobial (60%), MRSA (25%) | Vancomycin + Metronidazole | 21-28 days | 60% medical, 95% surgical |
| Mucormycosis | Rhizopus (70%), Mucor (20%) | Amphotericin B | 6-12 weeks | 40% survival |
⭐ Clinical Pearl: Mucormycosis shows black nasal eschar in 60% of cases, ketoacidosis in 80% of diabetic patients, and rapid progression with orbital apex involvement within 48-72 hours. Mortality reaches 25% without immediate surgical debridement plus amphotericin B 5mg/kg/day.
The sinus-orbital relationship explains 75% of orbital infections, with ethmoid sinusitis causing 85% of pediatric cases and sphenoid sinusitis producing orbital apex syndrome in 8% of adult cases. Understanding these anatomical pathways predicts infection severity and complications.

💡 Master This: The orbital compartment syndrome develops when intraorbital pressure >30mmHg compromises optic nerve perfusion. This occurs in 12% of orbital abscesses and requires immediate lateral canthotomy when vision deteriorates or afferent pupil defect develops, regardless of other clinical parameters.
📌 Remember: DRAIN indications for orbital abscess - Deteriorating vision, Restricted motility worsening, Afferent pupil defect, Increasing proptosis >2mm/24hrs, No improvement after 48-72 hours IV antibiotics. Surgical drainage required when ≥2 criteria present.
Connect these infectious patterns through neoplastic transformations to understand how orbital tumors present with distinct clinical signatures requiring specific diagnostic approaches.
An oncologist analyzes 150+ tumor markers and genetic mutations to design personalized treatment protocols with survival predictions accurate to 6-month intervals. Orbital tumors require similar systematic approaches where histologic type, anatomical location, and growth patterns determine treatment algorithms and prognostic outcomes based on evidence from large clinical series.
Orbital tumors demonstrate age-specific patterns with benign lesions predominating in children (85%) while malignant tumors increase with age (60% in adults >50 years). Understanding these epidemiologic patterns enables rapid differential diagnosis and appropriate treatment selection.

📌 Remember: CHILD tumors (benign) - Capillary hemangioma, Histocytosis, Inflammatory pseudotumor, Lymphatic malformation, Dermoid cyst. ADULT tumors (malignant risk) - Adenocarcinoma, Direct extension, Uveal melanoma, Lymphoma, Thyroid carcinoma. Age <10: 95% benign. Age >50: 40% malignant.

| Tumor Type | Age Peak | Location | Treatment | 5-Year Survival |
|---|---|---|---|---|
| Capillary Hemangioma | 0-2 years | Lid/superficial | Observation/steroids | 100% (benign) |
| Cavernous Hemangioma | 30-50 years | Intraconal | Complete excision | 100% (benign) |
| Rhabdomyosarcoma | 5-10 years | Any location | Chemo + radiation | 85% |
| Adenoid Cystic CA | 40-60 years | Lacrimal gland | Surgery + radiation | 40% |
| Lymphoma | 50-70 years | Extraconal | Radiation/chemo | 75% |
⭐ Clinical Pearl: Adenoid cystic carcinoma of lacrimal gland shows perineural invasion in 90% of cases, explaining pain in 70% of patients and high recurrence rates (60% at 10 years) despite aggressive treatment. Complete excision without biopsy prevents tumor seeding along biopsy tract.
The treatment algorithm depends on tumor biology rather than size alone. Slow-growing benign tumors may be observed even when large, while rapidly growing malignancies require immediate intervention regardless of size. Growth rate >2mm/month indicates malignancy in 85% of cases.

💡 Master This: Orbital lymphoma represents 55% of orbital malignancies in adults >50 years, with MALT lymphoma being most common (70%). Bilateral involvement occurs in 25% and indicates systemic disease requiring full staging workup. Radiation therapy alone achieves 95% local control for localized disease.
📌 Remember: STAGE orbital malignancy workup - Systemic examination, Tissue diagnosis, Anatomy (CT/MRI), General health assessment, Endocrine evaluation. Complete staging changes management in 40% of cases and determines prognosis more accurately than tumor size alone.
Connect these treatment algorithms through systemic disease manifestations to understand how orbital pathology integrates with multi-system conditions requiring coordinated care.
A systems biologist maps 10,000+ protein interactions across multiple organ systems, identifying network hubs where single mutations affect dozens of downstream pathways. Orbital diseases similarly function as systemic manifestations where thyroid dysfunction, autoimmune conditions, and vascular malformations create multi-organ syndromes requiring coordinated subspecialty management.
The orbit serves as a diagnostic window for systemic diseases, with orbital manifestations often preceding systemic symptoms by months to years. Understanding these disease networks enables early diagnosis and preventive interventions that improve long-term outcomes across multiple organ systems.

📌 Remember: SYSTEM orbital manifestations - Sarcoidosis (lacrimal glands), Yasculitis (orbital inflammation), Sjogren's (dry eye), Thyroid (orbitopathy), Endocrine (diabetes complications), Malignancy (metastases). Orbital signs precede systemic diagnosis in 35% of autoimmune diseases.

The autoimmune orbital syndrome encompasses multiple conditions sharing common pathways: molecular mimicry, cross-reactive antibodies, and inflammatory cascades. Orbital involvement occurs in 40% of systemic autoimmune diseases, often as the presenting manifestation.

| Systemic Disease | Orbital Manifestation | Frequency | Diagnostic Marker | Treatment Response |
|---|---|---|---|---|
| Graves' Disease | Orbitopathy | 25-50% | TSI antibodies | Steroids 70% |
| Sarcoidosis | Lacrimal enlargement | 15-25% | ACE elevation | Steroids 80% |
| Sjögren's Syndrome | Severe dry eye | 90-95% | Anti-Ro/La | Immunosuppression 60% |
| Wegener's Granulomatosis | Orbital mass | 15-20% | c-ANCA | Cyclophosphamide 85% |
| Giant Cell Arteritis | Ischemic optic neuropathy | 10-15% | ESR >50 | Steroids 90% |
⭐ Clinical Pearl: Giant cell arteritis causes anterior ischemic optic neuropathy in 15% of patients >50 years, with bilateral involvement in 25% within days to weeks. ESR >50 and CRP >2.45 have 97% sensitivity for diagnosis, requiring immediate steroids (1mg/kg prednisolone) to prevent irreversible blindness.
The vascular-orbital network demonstrates how systemic vascular diseases manifest with orbital complications. Carotid-cavernous fistulas produce orbital congestion, while arteriovenous malformations cause progressive proptosis and visual field defects through steal phenomena.
💡 Master This: Orbital metastases present with enophthalmos in 60% of scirrhous tumors (breast, gastric) due to tissue contraction, while expansile metastases (lung, kidney) cause proptosis. Bilateral orbital involvement indicates systemic disease with median survival <12 months.
📌 Remember: NETWORK approach to orbital disease - Neurologic (cranial nerves), Endocrine (thyroid, diabetes), Tumor (primary vs metastatic), Wasculitis (autoimmune), Oncologic (systemic malignancy), Rheumatologic (connective tissue), Kidney (systemic effects). Multi-system evaluation changes diagnosis in 45% of complex orbital cases.
Connect these systemic networks through rapid assessment tools to develop comprehensive clinical mastery frameworks for immediate diagnostic and therapeutic decision-making.
A trauma surgeon makes life-saving decisions within 60 seconds using systematic assessment protocols that evaluate 12+ critical parameters simultaneously. Orbital disease evaluation requires similar rapid assessment frameworks where systematic examination, pattern recognition, and decision algorithms enable accurate diagnosis and appropriate treatment within minutes of patient encounter.
The orbital examination protocol follows a systematic sequence evaluating visual function, motility patterns, anatomical relationships, and inflammatory signs to generate differential diagnoses ranked by probability and urgency. This structured approach prevents missed diagnoses and ensures appropriate triage.

📌 Remember: VISION examination sequence - Visual acuity, Inspection (lids, globe position), Supraduction/infraduction, Intraocular pressure, Optic nerve function, Neurologic assessment. Complete examination takes <5 minutes but identifies 95% of orbital pathology requiring urgent intervention.
| Clinical Finding | Measurement | Significance | Differential Diagnosis | Urgency Level |
|---|---|---|---|---|
| Proptosis >25mm | Hertel exophthalmometry | Severe space-occupying lesion | Tumor, abscess, hemorrhage | High |
| Vision <20/40 | Snellen chart | Optic nerve compromise | CON, AION, tumor | High |
| IOP >30mmHg | Goldmann tonometry | Orbital compartment syndrome | Hemorrhage, severe TED | Emergency |
| Afferent pupil defect | Swinging flashlight | Optic nerve dysfunction | Any compressive lesion | High |
| Complete ophthalmoplegia | Motility testing | Multiple nerve involvement | Apex syndrome, cavernous sinus | High |
⭐ Clinical Pearl: Orbital compartment syndrome requires immediate lateral canthotomy when IOP >30mmHg + vision deterioration + afferent pupil defect. Vision recovery depends on decompression within 2 hours of symptom onset, with permanent loss occurring after >6 hours of elevated pressure.


💡 Master This: The "24-48-72 rule" guides orbital infection management: 24 hours for clinical response to antibiotics, 48 hours for imaging if no improvement, 72 hours for surgical intervention if medical therapy fails. Earlier intervention required with vision changes or neurologic signs.
📌 Remember: URGENT orbital signs requiring immediate intervention - Unilateral vision loss, Rapid progression (<24 hours), Gaze restriction + pain, Elevated IOP >25mmHg, Neurologic deficits, Temperature >38.5°C. Any combination of ≥2 signs mandates emergency evaluation and treatment initiation within 1 hour.
The orbital disease mastery framework integrates anatomical knowledge, pathophysiologic understanding, pattern recognition, and treatment algorithms into a comprehensive approach that enables rapid diagnosis and optimal outcomes across the full spectrum of orbital pathology.
Signup to continue reading this lesson and unlimited access questions, flashcards, AI notes, and more
Have doubts about this lesson?
Ask Rezzy, your AI Study Mate, to explain anything you didn't understand
Get full Oncourse access with lessons, practice questions, flashcards and AI study tools.
Scan to download app